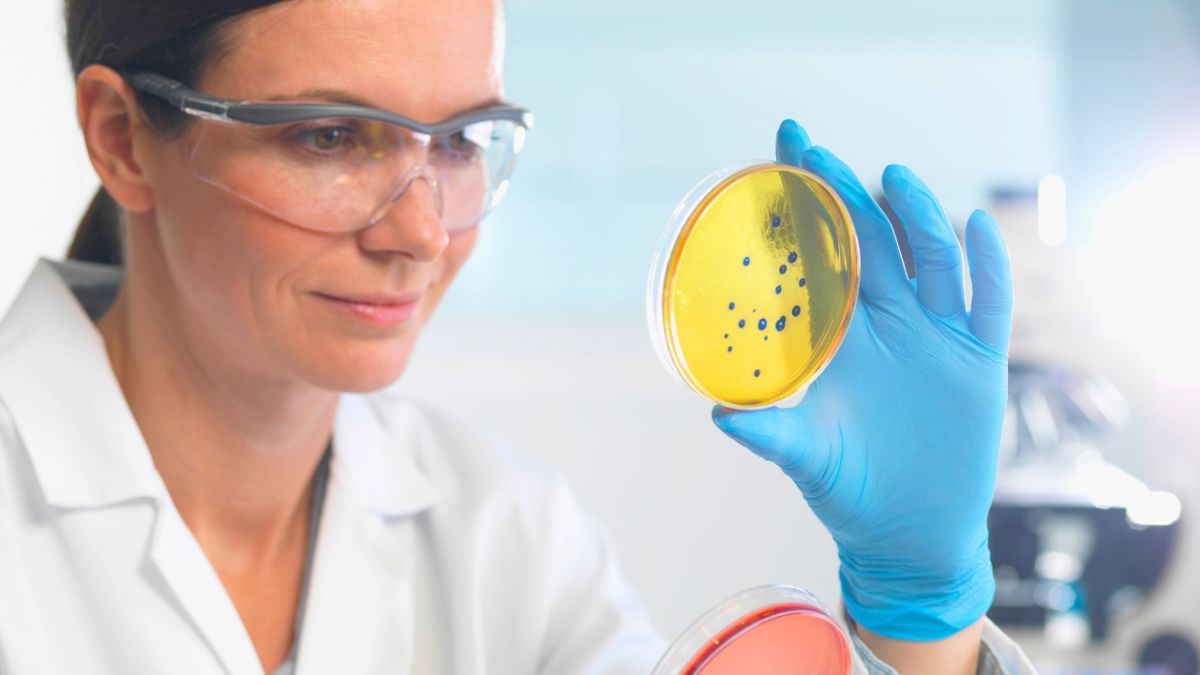

ماذا يعني مقاومة المضادات الحيوية؟
يُتوقَّع أن تودي مقاومة المضادات الحيوية التي غالبا ما يُستهان بها، بحياة 39 مليون إنسان في الربع المقبل من القرن، وقبل اجتماع رفيع المستوى الخميس على هامش مفاوضات الأمم المتحدة في نيويورك، تحدث ثلاثة ناجين من هذه المشكلة الصحية عن تجاربهم لوكالة فرانس برس.
في تشرين الأول/أكتوبر 2020، انزلق الطبيب البيطري جون كاريوكي موهيا في حمامه في نيروبي عاصمة كينيا، وكسر وركه. فخضع لعملية جراحية لوضع دبابيس في مفصله.
ويقول “مباشرة بعد العملية، أصبحت مريضا جدا”. فأُعطِيَ سلسلة كاملة من المضادات الحيوية، لكن من دون جدوى. والسيناريو نفسه حصل بعد عملية إزالة الدبابيس. وبات أطباؤه يخشون أن يموت. وفي تلك المرحلة أصيب بكوفيد. ويقول ” كنت أحارب من أجل البقاء”.

بعد خمسة أشهر أمضاها في المستشفى، عاد إلى منزله لكنه بقي طريح الفراش. ويعتبر أنه كان “محظوظا” لأنه درس في السابق مقاومة مضادات الميكروبات واشتبه في أنه يواجهها.
فأجرى اختبار الحساسية للمضادات الحيوية على 18 مضادا حيويا مختلفا، وتبيّن أنّه يعاني حساسية على إحداها. وفي تشرين الثاني/نوفمبر 2021 أُعلن شفاؤه.
لكنه بات “معوقا مدى الحياة”، إذ قصرت ساقه اليمنى بمقدار ثمانية سنتيمترات تقريبا. ويقول جون كاريوكي موهيا “نحن جميعا معرضون للخطر”، داعيا إلى التحرّك لمواجهة هذه المشكلة الصحية.
بالنسبة إلى أنطوني داركوفيتش، بدأ كل شيء في أوائل العقد الأول من القرن الحادي والعشرين خلال ممارسته البيسبول، عندما أصيب بتمزق في الكفة المدورة في كتفه الأيمن، وهي إصابة “غير بليغة” نسبيا للأطباء، على ما يقول هذا الرجل البالغ 34 عاما والذي يعيش حاليا في نيويورك.
مقاومة خطرة للمضادات الحيوية
خضع لسلسلة من العمليات الجراحية لتعود كتفه إلى طبيعتها ووقف الألم. وقبل كل عملية كان يتم إعطاؤه مضادات حيوية شائعة للوقاية من أي عدوى محتملة. وبعد العملية السابعة، اكتشف الأطباء وجود عدوى مقاومة للمضادات الحيوية في كتفه. ويقول إن “كل عملية أدت إلى زيادة انتشار العدوى”.
وخضع داركوفيتش لاثني عشر تدخّلا صحيا آخر لإزالة “المواد المصابة”، بينها براغ وغضاريف. كان مفصله “مدمرا بالكامل”، وتم استبدال كتفه بطرف اصطناعي. ويأمل أن يتمكن يوما ما من “رفع ذراعه إلى علوّ الكتف”.
وتختلف حالته عن حالات كثيرة أخرى لأن البكتيريا التي أصابت كتفه عادة ما تكون حميدة، وتسبب ظهور حب في البشرة. ولكن بما أنها أصبحت مقاومة للمضادات الحيوية، انتشرت في المفصل وتسببت بتلفه.

ويقول داركوفيتش الذي أصبح من المدافعين عن المرضى المصابين بعدوى مقاومة للمضادات الحيوية “نحن في عالم يمكننا غالبا فيه معالجة أنواع كثيرة من العدوى بفعالية كبيرة، ولكن مع مقاومة المضادات الحيوية، لم يعد هذا السيناريو قائما”.
كانت بهاكتي تشافان قد أنهت حديثا دراستها في بومباي بالهند عام 2017 عندما لاحظت تورّما في رقبتها. فوصف لها طبيبها مضادات حيوية لكنّ التورم لم يتقلّص، وفق ما تقول هذه الباحثة البالغة 30 عاما.
وبعد إجراء بعض الاختبارات، شُخّصت بالإصابة بمرض السل المقاوم للأدوية، وهو شكل شائع وخطر من الأمراض المقاومة للمضادات الحيوية.
لم تنجح مجموعة من الأدوية تناولتها على مرحلتين في تحسين وضعها، لكنّها تمكنت من الحصول على دواءين جديدين من خلال منظمة أطباء بلا حدود. وقد أدخلتها الآثار الجانبية التي كانت مؤلمة في كثير من الأحيان، في حالة من الاكتئاب، وأثنتها “وصمة العار” المرتبطة بمرض السل عن الحديث عن وضعها.
وبعد عامين من العلاج بثمانية مضادات حيوية مختلفة، بينها “حقن يومية مؤلمة لثمانية أشهر”، أصبحت تشافان بصحة جيدة.
لكنها تشعر بالقلق من ألا يولي قلة من الناس بمن فيهم الأطباء، أهمية كبيرة لخطر مقاومة المضادات الحيوية.
وتحذر من أنّ “هذه المشكلة الصحية قد تحدث لأي شخص”.